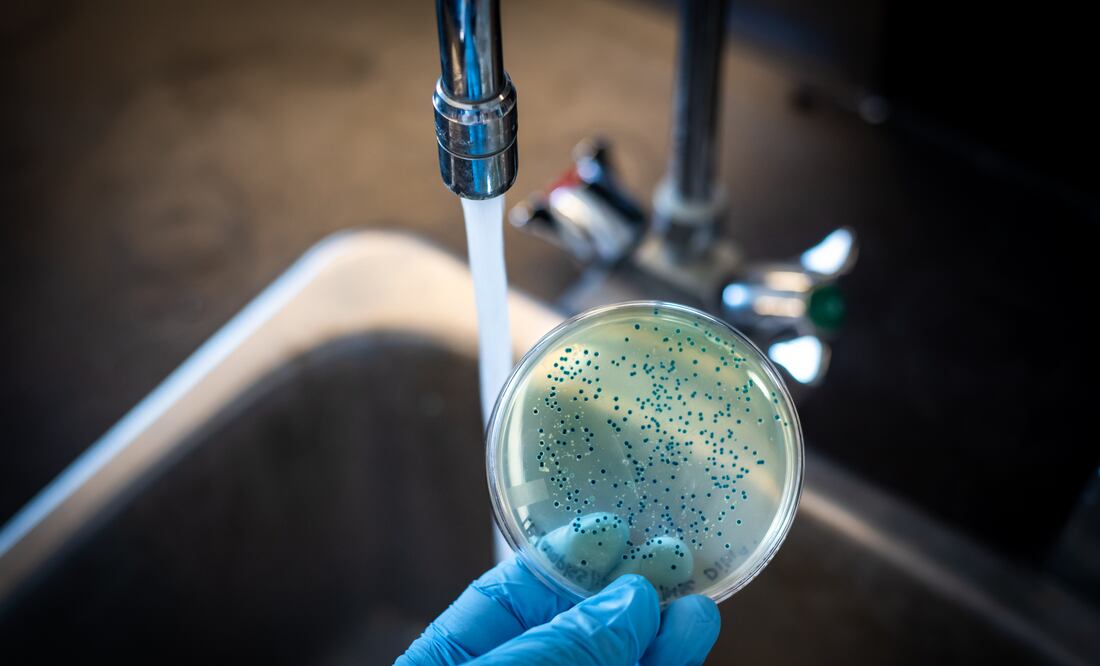
La OMS alerta de un resurgimiento de los casos globales de cólera. Foto iStock / Manjurul

TE RECOMENDAMOS
La enfermedad del cólera está resurgiendo en el mundo, con brotes cada vez más grandes y en más países, advirtió hoy la Organización Mundial de la Salud (OMS) tras analizar las estadísticas más recientes.
Según estos datos, 44 países reportaron brotes de cólera en 2022, un 25 % más que en 2021, y entre ellos siete sufrieron epidemias que afectaron a más de 10.000 personas (Afganistán, Camerún, la República Democrática del Congo, Malaui, Nigeria, Somalia y Siria).
La OMS advierte además de que la crisis climática influye en este resurgimiento del cólera, ya que a veces los brotes se producen tras desastres naturales tales como inundaciones o ciclones, cuya frecuencia está aumentando con el calentamiento global.
El cólera es una infección intestinal aguda causada por una bacteria, que suele contraerse por la ingestión de alimentos o agua contaminados, habitualmente en lugares con malas condiciones de higiene, tales como zonas en conflicto o subdesarrolladas.
La agencia sanitaria de la ONU ha solicitado a los Estados miembros y otros donantes 160 millones de dólares para responder al cólera en su plan de respuesta para emergencias 2023-2024.
El cólera, una enfermedad transmitida por el consumo de agua o alimentos contaminados, es una preocupación creciente en el ámbito del turismo internacional. Aunque no es común en países desarrollados, las regiones con acceso limitado a servicios de agua potable y saneamiento a menudo enfrentan brotes de cólera que pueden afectar la seguridad de los viajeros y tener un impacto negativo en la industria turística.
¿Qué es el cólera?
El cólera es una enfermedad intestinal aguda causada por la bacteria Vibrio cholerae. Los síntomas incluyen diarrea acuosa profusa, vómitos y deshidratación severa. La rápida pérdida de líquidos puede llevar a un estado de shock y, en casos no tratados, a la muerte en cuestión de horas.
¿Cómo se contagia el cólera?
El cólera se propaga principalmente a través del consumo de agua o alimentos contaminados con las heces de una persona infectada.
Brotes de Cólera y su Impacto en el Turismo
En áreas donde las condiciones de saneamiento son deficientes y el acceso al agua potable es limitado, los brotes de cólera son comunes. Estos brotes pueden propagarse rápidamente y afectar a la población local, pero también representan un riesgo para los turistas que visitan estas regiones.
Cuando se reportan casos de cólera en un destino turístico, los viajeros pueden sentirse preocupados y optar por cancelar o cambiar sus planes de viaje. Además, las advertencias de salud y las restricciones de viaje pueden desalentar a los turistas a visitar áreas afectadas por brotes de cólera, lo que tiene un impacto económico negativo en la industria del turismo.
Prevención y Precauciones para los Viajeros
Para los turistas que planean visitar áreas donde el cólera es endémico o se han reportado brotes, es crucial tomar precauciones adecuadas para reducir el riesgo de contraer la enfermedad. Algunas medidas importantes incluyen:
- Consumir agua segura: Beber agua embotellada sellada o agua que haya sido previamente hervida o desinfectada. Evitar el hielo en las bebidas y no consumir alimentos lavados con agua no segura.
- Buena higiene: Lavarse las manos regularmente con agua y jabón, especialmente antes de comer o después de usar el baño. Llevar desinfectante de manos en caso de que no haya acceso a instalaciones de lavado de manos.
- Alimentos seguros: Optar por alimentos cocidos y calientes, evitando frutas y verduras crudas que puedan haber sido lavadas con agua no segura.
- Vacunación: Consultar con un profesional de la salud sobre la posibilidad de recibir la vacuna contra el cólera antes de viajar a áreas de riesgo.
- Conciencia local: Mantenerse informado sobre la situación de salud en el destino y seguir las recomendaciones de las autoridades de salud locales y organizaciones internacionales.
[Publicidad]